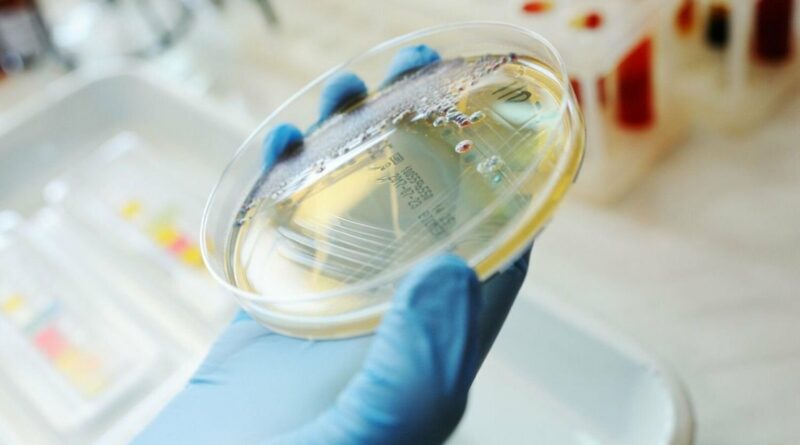

Las compañías Cites (perteneciente al Grupo SancorSeguros) y Uovo (perteneciente a la biotencológica Terragene) anunciaron, en Santa Fe, una alianza estratégica para desarrollar una startup biotecnológica asociada a la producción de antibióticos.
Se trata de Pepton, que se especializará en investigación y desarrollo de soluciones biomoleculares avanzadas, para brindar alternativas al uso de antibióticos tradicionales en las áreas de salud y producción animal.
Así lo difundieron ambas empresas en un comunicado conjunto. Desde el punto de vista científico, las investigaciones financiadas y coordinadas por Pepton se centrarán en “la optimización de biomoléculas peptídicas para el control de infecciones”, una respuesta ante el aumento de la resistencia bacteriana a los antibióticos.

Cites
Cites es un fondo “venture capital, inversor en deep tech. Funciona bajo el paraguas del Grupo Asegurador SanCor, nacido en Sunchales, Santa Fe. Terragene, la firma fundada en Rosario por los científicos y emprendedores, Esteban Lombardía y Adrián Rovetto, destinó USD 6 millones para poner en marcha Uovo, la plataforma de creación de compañías biotecnológicas.
Pues bien, a través de CITES, el Grupo SancorSeguros decidió invertir en esta nueva empresa de base tecnológica incubada por Uovo.
El modelo de negocio de Uovo se divide en Uovo Factory, donde se generan iniciativas propias bajo una rigurosa evaluación científica y de viabilidad, y Uovo Labs, que proporciona equipamiento de última generación para impulsar la innovación en el ecosistema biotecnológico argentino.
Uovo busca generar soluciones para sectores industriales del agro, la salud, la cosmética, los alimentos y el wellness, entre otras.

“Esta asociación marca un hito histórico en la inversión y el impulso de proyectos de alta relevancia científica y tecnológica”, sostienen en el comunicado. Además, adelantan que “la inversión inicial en Pepton es sólo el primer paso de lo que anticipamos como una serie de proyectos innovadores “que marcarán la pauta en la revolución biotecnológica”.
Ambas empresas tienen expectativa en fortalecer y ampliar su alianza estratégica en el futuro mediante nuevas coinversiones.
Seguí leyendo:
Terragene coloca obligaciones negociables por u$s 1,5 millones en busca de expandirse
Terragene refuerza la producción de hisopos nasofaríngeos
Terragene invertirá US$ 21 millones en productos biotecnológicos para el control de plagas